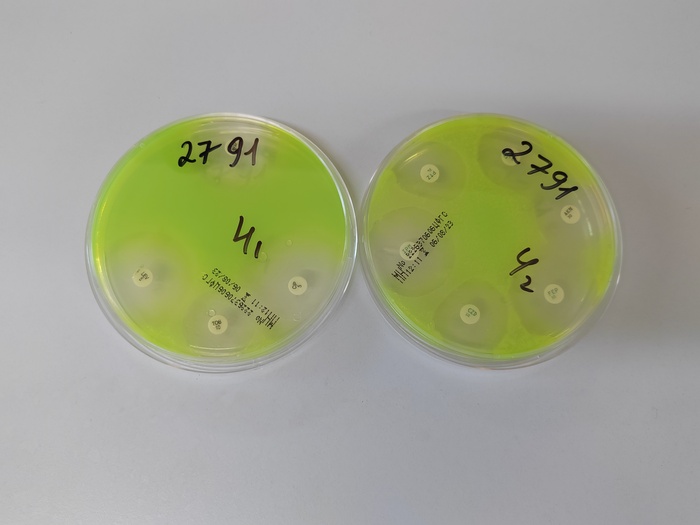

Профессия - врач клинический микробиолог
На волне постов про профессии я упомянула и о своей. Она действительно оч редкая и о ней мало кто знает. Так вот, наконец-то я написала пост про свою специальность)
Напомню, я работаю медицинским микробиологом. Мало кто знает, кто ж это такой. Рассказываю:
Медицинский микробиолог это врач, который выделяет микробы из биоматериала, идентифицирует ( опознаёт ху из ху) их, оценивает клиническую значимость (понимает вот точно в данном конкретном случае у конкретного пациента именно этот вид микроба может вызвать болезнь) и определяет антибиотикограмму (подбирает препарат, который, в лабораторных условиях, эффективнее подействует именно на этот микроб).
Кстати, вот так представляют нас нейросети. Жутковатенько и далеко от истины
Мы не занимаемся взятием биоматериала. Самое частое заблуждение про нас "вы в г..не постоянно ковыряетесь!" Нам всё приносят. Обрабатывают первично тоже не врачи, а средний мед персонал. Казалось бы, а чем же занимается врач? Вообще непыльная работка, за него ж всё сделали! А занимаемся мы как раз оценкой того, что выросло.
Вот так выглядит наше горло, а точнее- зев. В нём - немало разных бактерий. Вот и в этой куче нам надо найти того, кто возможно вызвал проблемы. Это не всегда просто. Тут нужно учитывать многие факторы: откуда был взят материал? Какие симптомы у пациента? Что предполагает лечащий врач? Какие патогены наиболее часто встречаются в данном биоматериале? Какие микроорганизмы должны быть в норме? Ну и далее - идентифицировать микробики, которые подозрительны.
Микромир кране разнообразен. Для каждого микроба - свой набор тестов и свой путь идентификации. Поэтому, в рамках этого поста всё показать и про всё рассказать - нереально. Если тема интересна, буду пилить посты про это. На фото выше - один из этапов идентификации.
Как и идентификация, чувствительность к каждому патогену подбирается индивидуально. Делаем мы это на основе знаний о строении микроба и особенностях его жизни. Конечно, учитываем особенности превращения препарата в организме человека и диагнозы, которые у него имеются. На фото - постановка чувствительности синегнойной палочки к антибиотикам
Вот такая работа. Многим- не видная. Многими, даже коллегами - недооценённая. Например, большинство людей, когда узнают, что я - бактериолог, искренне не понимают: "А зачем для этого заканчивать медицинский ?!" Поясню более подробно: для нашей работы важны знания всех врачебных дисциплин! А некоторые - мы изучаем более глубоко, чем лечащие врачи. Да, мы не лечим и не знаем дозировок препаратов, но мы прекрасно знаем: Что, где и как в организме человека должно работать,
Как и на что может повлиять его заболевания и состояния
как принимаемые им препараты и образ жизни могут повлиять на инфекцию
что где и как у микроба случается и работает и где ему положено быть, а где - нет
Чёт как-то заумно и душновато написала. Надеюсь понятно, чем таки я занимаюсь на работе) Если чёт не оч, с радостью отвечу на вопросы в комментах.